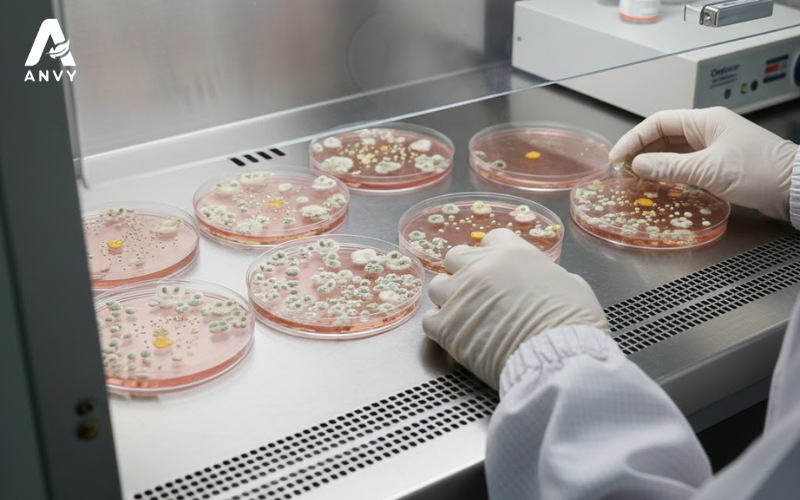

Phân tích 4 tiêu chí cốt lõi mà các nhà cung cấp phải đáp ứng để dược liệu nhập khẩu được chấp nhận sử dụng tại các cơ sở y tế, đảm bảo an toàn và hiệu quả điều trị.
Dược liệu nhập khẩu, đặc biệt từ Trung Quốc, đóng vai trò quan trọng trong hệ thống khám chữa bệnh bằng Y học cổ truyền tại Việt Nam. Tuy nhiên, việc kiểm soát chất lượng và an toàn luôn là mối quan tâm hàng đầu của các chuyên gia y tế do lo ngại về việc tẩm ướp hóa chất, nấm mốc và dư lượng độc hại.
Để đảm bảo hiệu quả điều trị và an toàn cho người bệnh, các nhà cung cấp dược liệu uy tín phải đáp ứng một quy trình đánh giá nghiêm ngặt, được thiết lập dựa trên 4 tiêu chí cốt lõi mà các cơ sở y tế bắt buộc phải tuân thủ khi tiếp nhận sản phẩm.
Tiêu chí 1: Kiểm tra đạt chuẩn dược điển và nguồn gốc
Tiêu chí đầu tiên mang tính pháp lý và nhận dạng sơ bộ, là yêu cầu cơ bản để đảm bảo dược liệu đúng loại và có hồ sơ rõ ràng.
1. Phù hợp với dược điển Việt Nam và dược điển Trung Quốc
Dược liệu khi cung cấp cho cơ sở y tế phải có hồ sơ kiểm nghiệm chứng minh đạt các tiêu chuẩn được quy định trong dược điển.
- Định danh chủng loại: Xác nhận tên khoa học (Latin) của dược liệu phải khớp với DĐVN. Ví dụ: Dược liệu thục địa phải là rễ củ cây Rehmannia glutinosa.
- Tiêu chuẩn cơ bản: Cần kiểm tra các chỉ tiêu cơ bản như độ ẩm, tỷ lệ tạp chất, và độ tro. Dược liệu đạt chất lượng phải có độ ẩm thấp (thường dưới 13%) để ngăn ngừa nấm mốc.
2. Đánh giá cảm quan và hồ sơ nguồn gốc
- Cảm quan: Dược liệu không được có màu sắc bất thường (quá sáng hoặc quá sẫm), không có mùi lạ (mùi hóa chất, lưu huỳnh) và không có dấu hiệu mối mọt, ẩm mốc.
- Hồ sơ kèm theo: Nhà cung cấp phải có đầy đủ chứng từ chứng minh nguồn gốc rõ ràng, bao gồm giấy chứng nhận phân tích (Certificate of Analysis – C.O.A) của nhà sản xuất, thể hiện việc kiểm soát chất lượng từ khâu nuôi trồng đến sản xuất.
Anvy đảm bảo tính minh bạch và truy xuất nguồn gốc bằng cách chỉ nhập khẩu và kiểm soát nguyên liệu từ các nguồn cung ứng đạt chuẩn GACP. Việc kiểm soát này được thực hiện ngay từ khâu đầu vào, đảm bảo hồ sơ rõ ràng và nguồn gốc an toàn cho từng lô dược liệu.

Tiêu chí 2: Kiểm soát dư lượng độc hại
Đây là tiêu chí an toàn bắt buộc quyết định dược liệu có được phép sử dụng trong điều trị hay không theo quy định của Bộ y tế.
1. Giới hạn kim loại nặng
Kim loại nặng (Asen, Chì, Cadimi, Thủy ngân) là vấn đề thường gặp do ô nhiễm môi trường đất hoặc trong quá trình chế biến thủ công. Dược liệu rễ củ, thân ngầm (như Hoài Sơn, Bạch Truật) hoặc các loại khai thác tự nhiên có nguy cơ tích lũy kim loại nặng cao hơn, cần được kiểm tra với tần suất nghiêm ngặt.
2. Dư lượng thuốc bảo vệ thực vật
Việc sử dụng thuốc trừ sâu quá mức trong canh tác dược liệu là nguyên nhân chính dẫn đến dư lượng này. Vì vậy, dược liệu phải được kiểm tra các nhóm thuốc trừ sâu phổ biến (như nhóm clo hữu cơ, phospho hữu cơ) và phải đạt giới hạn tiêu chuẩn cho phép để đảm bảo dược liệu không gây độc tính tích lũy lâu dài cho người bệnh.
Để kiểm soát nguồn dược liệu nhập không bị tồn dư kim loại nặng hay hóa chất độc hại, Anvy đã đầu tư vào phòng kiểm nghiệm đạt chuẩn chất lượng cao có trang bị hệ thống máy phân tích hiện đại như máy sắc ký khí khối phổ (GC-MS/MS) và thiết bị phổ hấp thụ nguyên tử (AAS – Atomic Absorption Spectrometry). Công nghệ này cho phép Anvy tự chủ kiểm tra chính xác các chỉ tiêu an toàn độc hại theo tiêu chuẩn WHO, đảm bảo mọi lô hàng nhập khẩu đều loại trừ rủi ro tồn dư hóa chất ở mức tối đa.

Tiêu chí 3: Đánh giá mức độ nhiễm vi sinh và nấm mốc
Vi sinh và nấm mốc không chỉ làm giảm chất lượng dược liệu mà còn tạo ra độc tố (Mycotoxin) cực kỳ nguy hiểm. Đây là một trong những yêu cầu khắt khe về bảo quản và chế biến.
1. Giới hạn vi khuẩn và nấm
- Kiểm tra tổng số: Các chỉ tiêu cần kiểm tra bao gồm tổng số vi khuẩn hiếu khí, tổng số nấm men và nấm mốc.
- Bắt buộc phải kiểm tra sự hiện diện của các vi khuẩn gây bệnh như E.coli và Salmonella. Sự hiện diện của các loại vi khuẩn này cho thấy dược liệu bị ô nhiễm nghiêm trọng trong quá trình thu hái hoặc bảo quản.
2. Kiểm soát Aflatoxin
Aflatoxin là một loại độc tố nấm mốc có chất gây ung thư mạnh, thường xuất hiện trong các dược liệu có hàm lượng dầu hoặc tinh bột cao (ví dụ: ý dĩ, mạch nha, các loại hạt).
Nhà cung cấp cần ưu tiên kiểm tra và cam kết về tiêu chí này, đặc biệt đối với dược liệu có nguồn gốc từ vùng khí hậu ẩm ướt hoặc đã bảo quản lâu.
Tiêu chí này đòi hỏi năng lực bảo quản tiên tiến. Hệ thống kho bãi đạt tiêu chuẩn GSP mà Anvy đang vận hành là yếu tố then chốt, giúp kiểm soát nhiệt độ và độ ẩm liên tục theo quy định của WHO, ngăn chặn hiệu quả sự phát triển của nấm mốc và việc hình thành độc tố Aflatoxin, bảo toàn chất lượng dược liệu.
Tiêu chí 4: Định tính và định lượng hoạt chất
Đây là cốt lõi để đảm bảo dược liệu có hiệu quả điều trị thực tế, không chỉ dừng lại ở mức độ an toàn mà tiêu chí này còn là yêu cầu cao nhất về mặt dược lý.
1. Định tính hoạt chất đặc trưng
- Mục đích: Xác nhận sự hiện diện của nhóm hoạt chất chính (ví dụ: alcaloid, flavonoid, saponin) bằng các phương pháp hóa học hoặc sắc ký lớp mỏng (TLC).
- Ý nghĩa: Giúp cơ sở y tế phát hiện dược liệu bị giả mạo hoặc pha trộn với các loại không có hoạt tính dược lý.
2. Định lượng hoạt chất chính
Đây là bước nâng cao, sử dụng các kỹ thuật phân tích hiện đại như HPLC (Sắc ký lỏng hiệu năng cao) để xác định hàm lượng của hoạt chất có tác dụng điều trị.
Ví dụ: Dược liệu sâm phải có hàm lượng Ginsenoside tối thiểu, hoặc Hoàng Liên phải đạt hàm lượng Berberin theo quy định. Hàm lượng hoạt chất thấp sẽ dẫn đến hiệu quả điều trị kém, làm giảm uy tín của chuyên môn y tế.
Anvy tập trung vào định hướng thảo dược chuẩn hóa, cam kết cung cấp nguyên liệu có hàm lượng hoạt chất chính được định lượng rõ ràng và ổn định. Điều này đảm bảo tác dụng dược lý thực tế cho các cơ sở điều trị, thay vì chỉ cung cấp dược liệu theo khối lượng đơn thuần.

KẾT LUẬN
Việc áp dụng đồng bộ 4 tiêu chí trên là cam kết bắt buộc của mọi nhà cung cấp dược liệu uy tín. Bằng cách đáp ứng triệt để các yêu cầu chuyên môn này, dược liệu mới có thể đảm bảo an toàn cho người bệnh và đóng góp vào hiệu quả điều trị cao nhất tại các cơ sở y tế.
Anvy là nhà cung cấp dược liệu uy tín đáp ứng đủ 4 tiêu chí, áp dụng mô hình kiểm soát chất lượng và phòng kiểm nghiệm hiện đại.
Hotline: 1800.234.558
